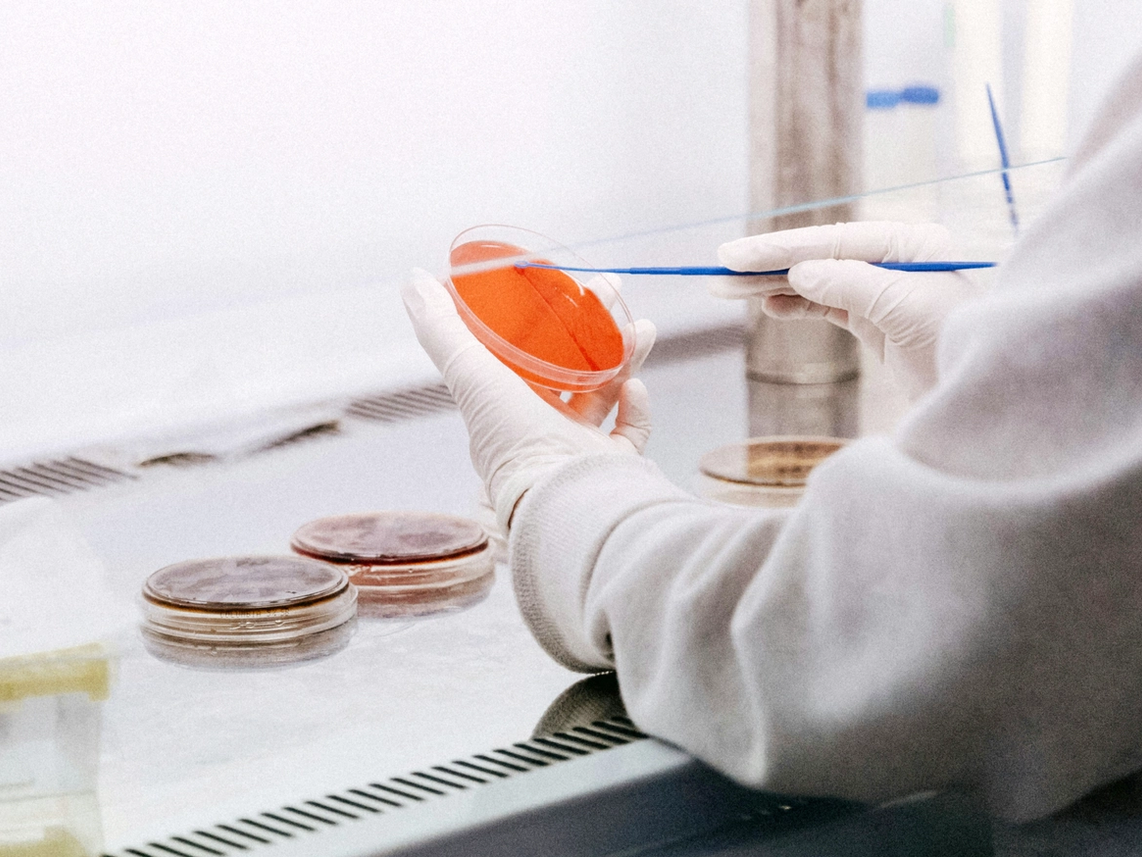

LSP 4
Key Facts
- Status
Active
- Launch
2008
- Size
88M EUR
- SFDR classification
-


Do You Want to Learn More?
We are eager to explore how we can achieve great things together.
Active
2008
88M EUR
-

We are eager to explore how we can achieve great things together.
Company | Sector | Market | Entry | Exit |
|---|---|---|---|---|
| Argenx | Life Sciences | Netherlands | 2009 | 2017 |
| Binx Health | Life Sciences | United Kingdom | 2021 | - |
| Celladon | Life Sciences | United States | 2012 | 2015 |
| Curetis | Life Sciences | Germany | 2009 | 2020 |
| Mendor | Life Sciences | Finland | 2011 | 2016 |
| Merus | Life Sciences | Netherlands | 2010 | - |
| Prosensa | Life Sciences | Netherlands | 2007 | 2015 |
| Sapiens | Life Sciences | Germany | 2011 | 2014 |
| Vectura (Activaero) | Life Sciences | Germany | 2011 | 2014 |
| Ventaleon | Life Sciences | Germany | 2012 | 2020 |
| Vivoryon Therapeutics | Life Sciences | Germany | 2009 | 2022 |